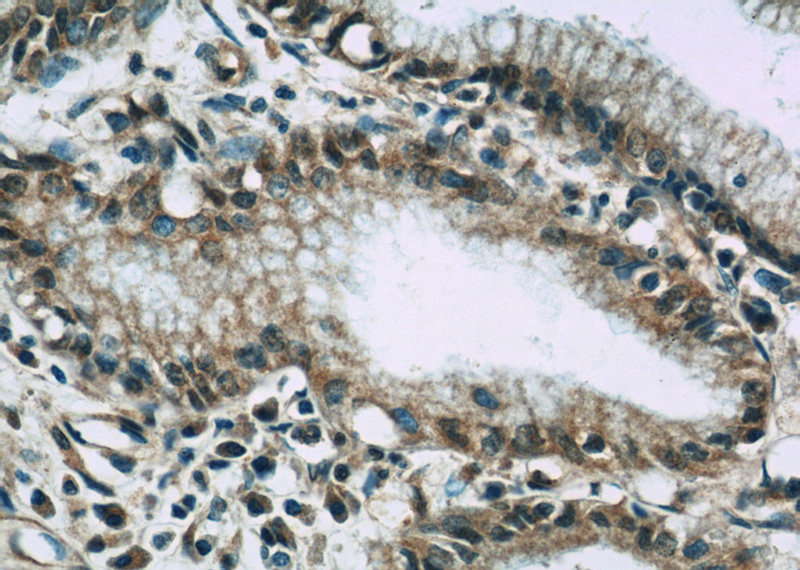

-
Product Name
VNN1 antibody
- Documents
-
Description
VNN1 Rabbit Polyclonal antibody. Positive IP detected in mouse kidney tissue. Positive WB detected in mouse kidney tissue, BxPC-3 cells, PC-13 cells. Positive IHC detected in human pancreas cancer tissue. Observed molecular weight by Western-blot: 55-72 kDa
-
Tested applications
ELISA, WB, IHC, IP
-
Species reactivity
Human, Mouse; other species not tested.
-
Alternative names
HDLCQ8 antibody; Pantetheinase antibody; Pantetheine hydrolase antibody; Tiff66 antibody; vanin 1 antibody; VNN1 antibody
-
Isotype
Rabbit IgG
-
Preparation
This antibody was obtained by immunization of VNN1 recombinant protein (Accession Number: NM_004666). Purification method: Antigen affinity purified.
-
Clonality
Polyclonal
-
Formulation
PBS with 0.02% sodium azide and 50% glycerol pH 7.3.
-
Storage instructions
Store at -20℃. DO NOT ALIQUOT
-
Applications
Recommended Dilution:
WB: 1:500-1:5000
IP: 1:200-1:2000
IHC: 1:20-1:200
-
Validations

mouse kidney tissue were subjected to SDS PAGE followed by western blot with Catalog No:116766(VNN1 antibody) at dilution of 1:300

Immunohistochemistry of paraffin-embedded human pancreas cancer slide using Catalog No:116766(VNN1 Antibody) at dilution of 1:50(under 10x lens)
Immunohistochemistry of paraffin-embedded human pancreas cancer slide using Catalog No:116766(VNN1 Antibody) at dilution of 1:50(under 40x lens)

IP Result of anti-VNN1 (IP:Catalog No:116766, 4ug; Detection:Catalog No:116766 1:800) with mouse kidney tissue lysate 4000ug.
-
Background
VNN1(Vascular non-inflammatory molecule 1) is also named as Vanin-1,Pantetheinase,Tiff66.It is a GPI-anchored 70-kDa protein with a high degree of homology with GPI-80 (also known as VNN2), a molecule expressed by human phagocytes and involved in leukocyte adhesion and migration.Vanin-1 is predominantly expressed by resident tissue cells and acts at the level of epithelial cells and surrounding hematopoietic cells by paracrine cysteamine release(PMID:17163446). The full length VNN1 has a signal peptide, a propeptide and six glycosylation sites. According to some authors, the variations which varied between 55 and 72kDa may be due to different degrees of glycosylation of the protein and cleavage(JOSE A et al. 2001).
-
References
- Povero D, Eguchi A, Niesman IR. Lipid-induced toxicity stimulates hepatocytes to release angiogenic microparticles that require Vanin-1 for uptake by endothelial cells. Science signaling. 6(296):ra88. 2013.
- Chen S, Zhang W, Tang C, Tang X, Liu L, Liu C. Vanin-1 is a key activator for hepatic gluconeogenesis. Diabetes. 63(6):2073-85. 2014.
- Povero D, Eguchi A, Li H. Circulating extracellular vesicles with specific proteome and liver microRNAs are potential biomarkers for liver injury in experimental fatty liver disease. PloS one. 9(12):e113651. 2014.
- Wilson R, Golub SB, Rowley L. Novel Elements of the Chondrocyte Stress Response Identified Using an in Vitro Model of Mouse Cartilage Degradation. Journal of proteome research. 15(3):1033-50. 2016.
Related Products / Services
Please note: All products are "FOR RESEARCH USE ONLY AND ARE NOT INTENDED FOR DIAGNOSTIC OR THERAPEUTIC USE"
